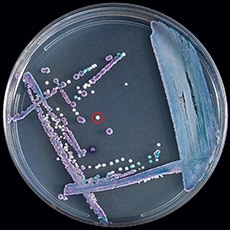
Artificiallymixedplate230px.png Petri dish with mixed culture ofCandida glabrata (purple), Candida tropicalis (navy blue), and Candida auris (white, circled in red) on CHROMagar Candida.

What to know
- Report confirmed cases of Candida auris (C. auris) to local and state public health officials and CDC at candidaauris@cdc.gov.
- On CHROMagar, C. auris colonies usually appear white or pink, but some colonies may look red or purple.
- C. auris grows well at 40 to 42 degrees Celsius.

Reporting
Healthcare facilities or laboratories that suspect they have a patient with C. auris infection should contact state or local public health authorities and CDC (candidaauris@cdc.gov) immediately for guidance.
When to suspect C. auris
C. auris can be misidentified as a number of different organisms when using traditional phenotypic methods for yeast identification. These methods include VITEK 2 YST, API 20C, BD Phoenix yeast identification system, and MicroScan.
The table below summarizes common misidentification based on the identification method used. Use appropriate methodology for further characterization if:
- Any of the species listed below are identified.
- The species identity cannot be determined.
Please note that this list is based on current knowledge about C. auris misidentification. It may change as we learn more about misidentification of C. auris.
| Identification Method | Organism C. auris can be misidentified as |
|---|---|
| Vitek 2 YST* | Candida haemulonii Candida duobushaemulonii |
| API 20C | Rhodotorula glutinis (characteristic red color not present) Candida sake |
| API ID 32C | Candida intermedia Candida sake Saccharomyces kluyveri |
| BD Phoenix yeast identification system | Candida haemulonii Candida catenulata |
| MicroScan | Candida famata Candida guilliermondii** Candida lusitaniae** Candida parapsilosis** |
| RapID Yeast Plus | Candida parapsilosis** |
Refer to detailed algorithms for when to suspect C. auris based on identification methods.
*There have been reports of C. auris being misidentified as Candida lusitaniae and Candida famata on VITEK 2. A confirmatory test such as cornmeal agar may be warranted for these species.
**On cornmeal agar, C. guilliermondii, C. lusitaniae, and C. parapsilosis generally make pseudohyphae and C. auris does not make hyphae or pseudohyphae. If hyphae or pseudohyphae are not present on cornmeal agar, any C. guilliermondii, C. lusitaniae, and C. parapsilosis isolates identified on MicroScan or any C. parapsilosis isolates identified on RapID Yeast Plus should be submitted for further identification.
Culture presentations
An increase in infections due to unidentified Candida species in a patient care unit should prompt suspicion for C. auris since C. auris can be transmitted in healthcare settings. Increases in isolation of Candida from urine specimens should also be monitored.
The appearance and color of C. auris colonies in culture may aid in species identification but cannot be used as the only identification method for C. auris. C. auris cannot be distinguished from other more common species of Candida without using other methods described below. C. auris is a budding yeast, which rarely forms short pseudohyphae and does not form germ tubes.
Some strains form aggregates of cells, whereas others do not. Unlike most other Candida species, C. auris grows well at 40–42º C. On most traditional chromogenic media, C. auris colonies usually appear white or pink, but some colonies may look red or purple. New chromogenic media have been developed that further facilitate identification of C. auris.

How to identify C. auris
Diagnostic devices
Diagnostic devices based on matrix-assisted laser desorption/ionization time-of-flight (MALDI-TOF) can differentiate C. auris from other Candida species. However, not all the reference databases included in MALDI-TOF devices allow for detection.
Accurate identification of C. auris can be performed using:
- Bruker Biotyper brand MALDI-TOF using the updated Bruker FDA-approved MALDI Biotyper CA System library (Version Claim 4) or their "research use only" libraries (Versions 2014 [5627] and more recent)
- BioMérieux VITEK (MALDI-TOF) MS using the FDA-approved IVD v3.2 or their "research use only" libraries (with Saramis Ver 4.14 database and Saccharomycetaceae update).
Supplemental MALDI-TOF databases
Supplemental MALDI-TOF databases that include additional C. auris strains from all four of the phylogenetic major clades (Clades I - IV) may enable users to overcome identification challenges. This is done by providing consistently higher MALDI identification scores.
MicrobeNet is one example of a free online MALDI database of rare and unusual pathogens that is curated by CDC experts. MicrobeNet users will have access to CDC C. auris MALDI spectral libraries as well as Bruker's most up-to-date database (all free with your MicrobeNet login).
Molecular methods
Molecular methods based on sequencing the D1-D2 region of the 28s rDNA or the Internal Transcribed Spacer Region (ITS) of rDNA can identify C. auris.
The GenMark ePlex Blood Culture Identification Fungal Pathogen (BCID-FP) Panel and BioFire FilmArray BCID2 have been FDA approved as molecular tests for C. auris identification in positive blood cultures.
PCR Methods
There are currently no high throughput FDA-approved tests for colonization swabs. Various PCR methods have been developed for detecting C. auris and are available in the scientific literature. The CDC PCR protocol is available here.
When choosing a PCR method to validate, factors to consider include the sensitivity and specificity of the technique, available laboratory capacity and equipment, whether the method was clinically evaluated with a comparable clinical sample type, the cost, and the turnaround time to results.
As of version 8.01, the Vitek 2 was found to consistently identify some, but not all, clades of C. auris, so all Candida haemulonii species complex isolates should be forwarded for further identification.
Sending isolates to CDC for identification
As C. auris continues to gain recognition, updated versions of other yeast identification platforms may be able to identify C. auris; please consult the instrument manufacturer for more information.
Laboratories with capability to characterize isolates further when C. auris is suspected are encouraged to do so. Suspected isolates can also be sent to CDC's AR Lab Network for identification and antifungal susceptibility testing. This testing is performed free of charge and may require coordination through the state public health department's Healthcare-associated Infection (HAI) Program.
Isolates should be submitted on slants shipped at room temperature. C. auris can grow on blood or chocolate agar slants; mycology-specific media are not necessary if the laboratory does not have them. To learn more about using the AR Lab Network and to find a listing of AR Lab Network regional laboratories, visit CDC's AR Lab Network. Additionally, CDC and some state public health laboratories can assist with C. auris isolate identification.
For laboratories interested in performing C. auris colonization testing in-house, guidance on processing swabs to assess for C. auris colonization is available under Guidance for Detection of Colonization of Candida auris.